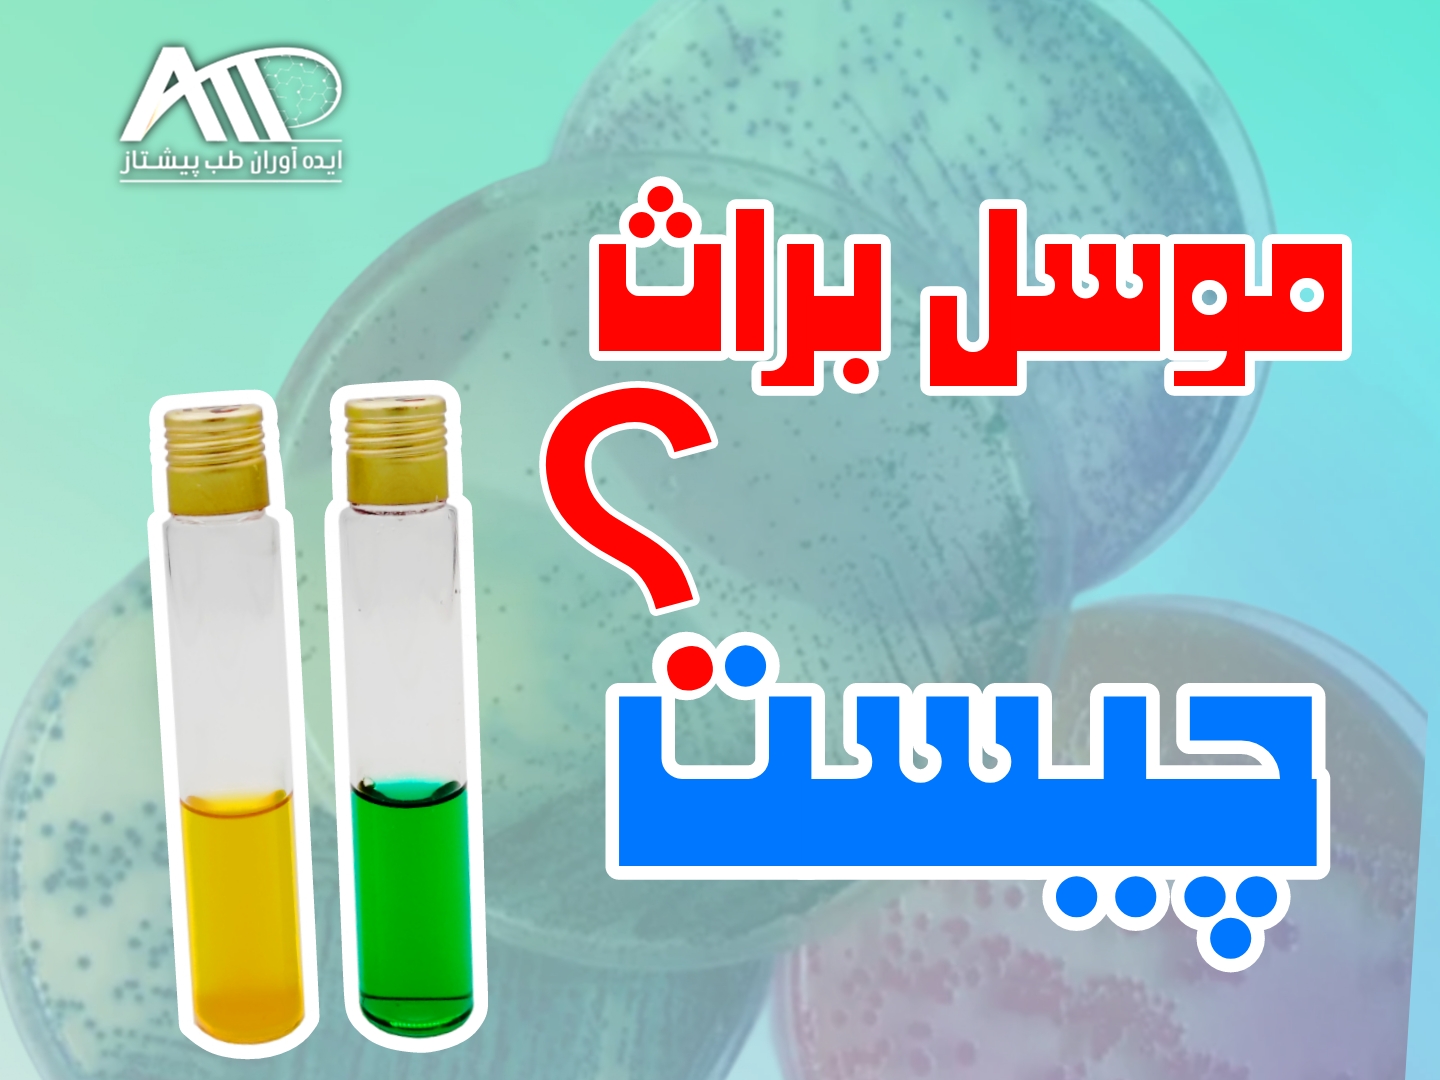
موسل براث چیست؟ راهنمای خرید موسل براث مرک

در صنایع غذایی، دارویی و آزمایشگاههای کنترل کیفیت، شناسایی دقیق باکتریهای بیماریزا اهمیت بسیار بالایی دارد. یکی از مهمترین باکتریهای مولد مسمومیت غذایی، Bacillus cereus است. برای جداسازی و شمارش این میکروارگانیسم از محیطهای کشت اختصاصی استفاده میشود که یکی از پرکاربردترین آنها موسل براث (Mossel Broth) است.
اگر به دنبال خرید موسل براث مرک (Merck) اصل با ضمانت کیفیت هستید، شرکت ایدهآوران طب پیشتاز بهعنوان تأمینکننده تخصصی محیطهای کشت میکروبی، این محصول را با تضمین اصالت ارائه میدهد.

موسل براث موس براث مرک محیط کشت موسل براث مرک موسل براث چیست ای ای موسل براث ماسل براث مرک خرید محیط کشت موسل براث مرک
موسل براث چیست؟
Mossel Broth یک محیط کشت انتخابی غنیشده است که برای تشخیص و شمارش Bacillus cereus در نمونههای غذایی طراحی شده است.
این محیط به نام دانشمند هلندی "Mossel" نامگذاری شده و در استانداردهای بینالمللی میکروبیولوژی مواد غذایی معرفی شده است.
کاربرد موسل براث :
مهمترین کاربردهای موسل براث عبارتند از:
- شناسایی Bacillus cereus در مواد غذایی
- کنترل کیفیت محصولات لبنی
- بررسی آلودگی برنج، گوشت و غذاهای آماده
- آزمونهای میکروبی صنایع غذایی
- آزمایشگاههای کنترل کیفی مطابق استاندارد ISO
ترکیبات موسل براث :
طبق منابع میکروبیولوژی و دیتاشیت رسمی مرک، ترکیبات این محیط شامل:
- Peptone (منبع نیتروژن)
- Mannitol
- عصاره مخمر
- نمکهای معدنی
- عوامل انتخابی مانند Polymyxin (در نسخه آگار)
وجود عوامل انتخابی باعث مهار رشد باکتریهای مزاحم و تقویت رشد Bacillus cereus میشود.
موسل براث مرک (Merck) :
برند Merck آلمان یکی از معتبرترین تولیدکنندگان محیطهای کشت میکروبی در جهان است. محیطهای کشت مرک به دلیل:
✔ کیفیت یکنواخت
✔ کنترل کیفی دقیق
✔ تطابق با استاندارد ISO 7932
✔ ارائه Certificate of Analysis (COA)
✔ بستهبندی ایمن و استاندارد
در آزمایشگاههای مرجع و صنایع بزرگ غذایی مورد استفاده قرار میگیرند.
استفاده از موسل براث مرک اصل تضمینکننده دقت و تکرارپذیری نتایج آزمایشگاهی است.
موسل براث موس براث مرک محیط کشت موسل براث مرک موسل براث چیست ای ای موسل براث ماسل براث مرک خرید محیط کشت موسل براث مرک
استانداردهای مرتبط با موسل براث:
موسل براث در آزمونهای زیر کاربرد دارد:
- ISO 7932 (شمارش Bacillus cereus)
- FDA BAM
- استانداردهای کنترل کیفی صنایع غذایی
در آزمایشگاههایی که مطابق با GMP و ISO 17025 فعالیت میکنند، استفاده از برند معتبر مانند Merck اهمیت ویژهای دارد.
راهنمای خرید موسل براث مرک :
هنگام خرید موسل براث به نکات زیر توجه کنید:
✅ اصالت برند Merck
✅ داشتن بچ نامبر معتبر
✅ ارائه COA
✅ تاریخ تولید جدید
✅ شرایط نگهداری مناسب
به دلیل حساسیت آزمونهای میکروبی، خرید از تأمینکننده معتبر بسیار مهم است.

موسل براث موس براث مرک محیط کشت موسل براث مرک موسل براث چیست ای ای موسل براث ماسل براث مرک خرید محیط کشت موسل براث مرک
خرید موسل براث مرک از ایدهآوران طب پیشتاز :
شرکت ایدهآوران طب پیشتاز تأمینکننده تخصصی:
- محیطهای کشت مرک
- مواد شیمیایی آزمایشگاهی Merck
- محیطهای کشت میکروبیولوژی صنایع غذایی
- کیتهای کنترل کیفی
مزایای خرید از ایدهآوران طب پیشتاز :
✔ تضمین اصالت کالا
✔ ارائه مستندات فنی (COA و MSDS)
✔ مشاوره تخصصی پیش از خرید
✔ ارسال سریع به سراسر کشور
✔ قیمت رقابتی برای خرید عمده
برای استعلام قیمت روز موسل براث مرک با کارشناسان فروش تماس بگیرید.
شرایط نگهداری موسل براث :
- نگهداری در محیط خشک و خنک
- دور از نور مستقیم
- دمای توصیهشده 10 تا 30 درجه سانتیگراد
- بستن کامل درب پس از استفاده
جمع بندی :
موسل براث (Mossel Broth) یکی از محیطهای کشت کلیدی در صنایع غذایی برای تشخیص Bacillus cereus است. استفاده از برند معتبر Merck آلمان باعث افزایش دقت، اطمینان و تکرارپذیری نتایج آزمایشگاهی میشود.
اگر به دنبال خرید مطمئن و حرفهای موسل براث مرک اصل هستید، شرکت ایدهآوران طب پیشتاز بهعنوان تأمینکننده تخصصی محیطهای کشت و مواد آزمایشگاهی، همراه قابل اعتماد شما خواهد بود.
موسل براث موس براث مرک محیط کشت موسل براث مرک موسل براث چیست ای ای موسل براث ماسل براث مرک خرید محیط کشت موسل براث مرک
موسل براث موس براث مرک محیط کشت موسل براث مرک موسل براث چیست ای ای موسل براث ماسل براث مرک خرید محیط کشت موسل براث مرک
منابع :
- ISO 7932 – Microbiology of Food and Animal Feeding Stuffs
- FDA Bacteriological Analytical Manual (BAM)
- Merck Microbiology Manual
- Food Microbiology – Jay, Loessner & Golden

دیدگاه خود را بنویسید